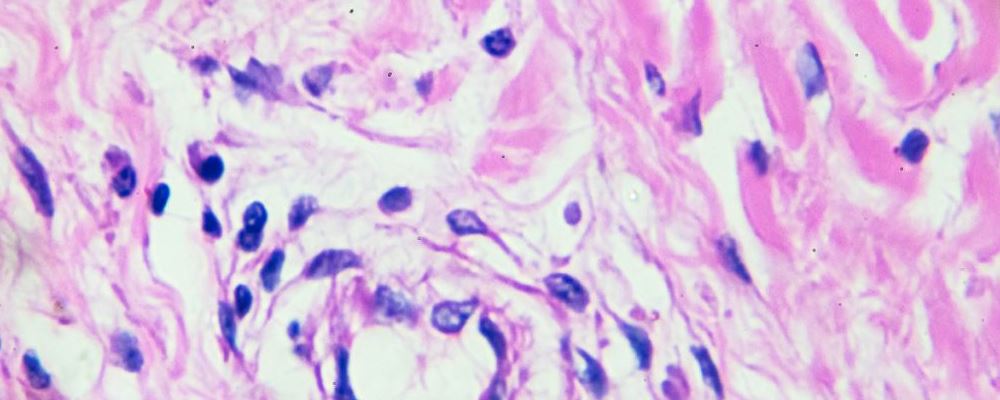
抗癌果蔬首选南瓜

养分专家指出,南瓜养分价值非常丰厚,而且已有现代医学研究成果证明,南瓜有必定的抗癌效果,能够有用防备膀胱癌、胃癌等病症。关于身体素质欠好的人来说,吃些南瓜肯定有益无害。
1、南瓜中还含有一种能分化亚硝胺的酶,对防备癌症有重要意义。
2、南瓜中所含的维生素C,可避免硝酸盐在消化道中转变成致癌物质亚硝胺,可防备食管癌和胃癌。
3、南瓜中含有甘露醇的物质,具有较好的通大便效果,能够削减粪便中毒素对人体的损害,关于避免结肠癌的产生有成效。
4、南瓜中所含维生素A的衍生物,能够下降机体对致癌物质的灵敏程度,能够安稳上皮细胞,避免其癌变,防备肺癌、膀胱癌癌等。
健康小贴士:蒜头豆豉煮番瓜
南瓜虽养分,素体胃热炽盛者少食;南瓜性偏雍滞,气滞中满者,慎食。引荐吃南瓜能够做成“蒜头豆豉煮番瓜”,蒜头具有解除湿毒的特性,正好拿来抑制南瓜的毒性,一起爽滑可口,吃下去满嘴留香:
【资料】南瓜400克,豆豉20克,蒜头2~3瓣,生姜1块
【预备】南瓜剥皮切薄片,豆豉洗洁净后参加蒜头和生姜剁烂
【过程】
热油锅,爆香蒜蓉豆豉;
参加南瓜,爆炒1~2分钟;
参加刚好能够没过南瓜的水;
大火煮开,转中火煮15分钟左右;
煮至水将干,放少数盐、白糖,或鸡精调味即可,豆豉比较咸,放盐要注意不必太多,装碟。






